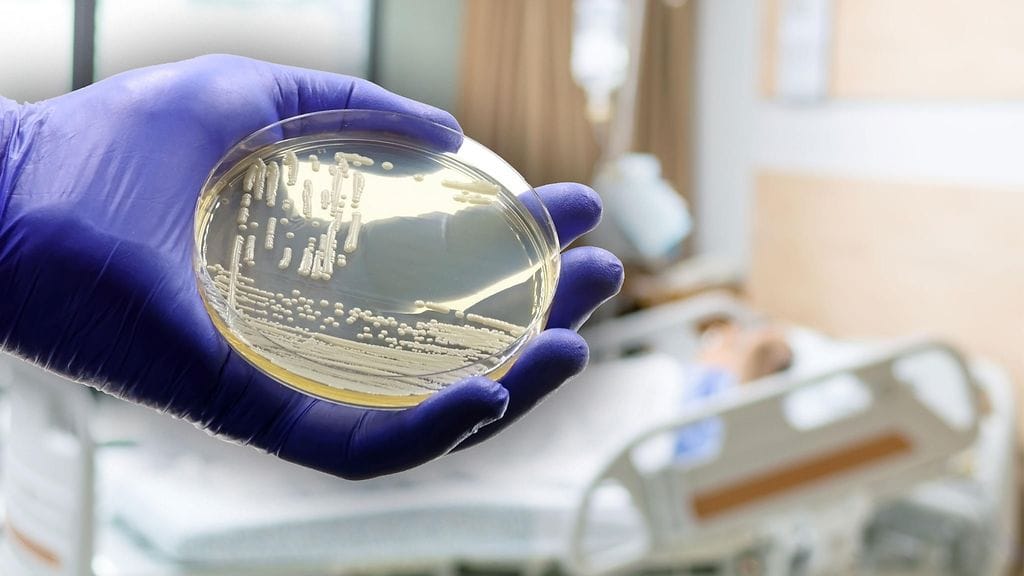
C. auris aiheuttaa vakavia yleisinfektioita. Kuvituskuva.

Candida auris -hiivasieni pelottaa maailmalla. Voisiko se alkaa levitä Suomessa?
Candida auris -nimellä tunnettu hiivasieni soittaa hälytyskelloja maailmalla. Saksalainen Bild-lehti uutisoi sienen "maailmanvalloituksesta" elokuussa 2025.
– Lääkärit kutsuvat sitä "painajaismaiseksi taudinaiheuttajaksi", lehti kuvasi.
C. auris aiheuttaa vakavia yleisinfektioita ja muita infektioita, kertoo THL. Se on erityisen vaarallinen sairaala- ja laitoshoitopotilaille, joilla on vakavia perussairauksia.
Lääkkeille hyvin vastustuskykyinen hiivasieni on poikkeuksellisen sitkeä ja luokiteltu Yhdysvalloissa kiireellisiä toimia vaativaksi terveysuhaksi.
Sieni on aiheuttanut esimerkiksi neljä laajaa epidemiaa Espanjassa ja Isossa-Britanniassa vuosina 2015–2017.
Havaittu Suomessa 2021, yhteensä 11 tapausta
Candida auris -hiivasieni on Suomessa harvinainen.
– Ensimmäinen C. auris -tapaus löydettiin vuonna 2021, ja vuosina 2022 ja 2023 tapauksia oli molempina vuosina kaksi, vuonna 2024 neljä ja tänä vuonna tapauksia on ollut tähän mennessä kaksi. Eli yhteensä siis 11, kertoo THL:n erikoistutkija Laura Lindholm.